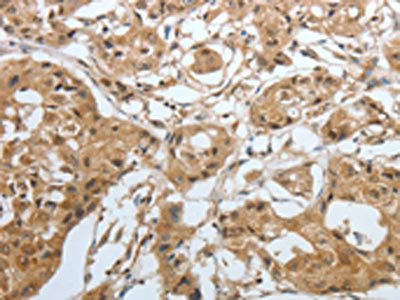

AMPH Antibody
-
中文名稱:AMPH兔多克隆抗體
-
貨號:CSB-PA796280
-
規格:¥1100
-
圖片:
-
The image on the left is immunohistochemistry of paraffin-embedded Human ovarian cancer tissue using CSB-PA796280(AMPH Antibody) at dilution 1/30, on the right is treated with fusion protein. (Original magnification: ×200)
-
The image on the left is immunohistochemistry of paraffin-embedded Human lung cancer tissue using CSB-PA796280(AMPH Antibody) at dilution 1/30, on the right is treated with fusion protein. (Original magnification: ×200)
-
Gel: 10%SDS-PAGE, Lysate: 60 μg, Lane: Mouse lung tissue, Primary antibody: CSB-PA796280(AMPH Antibody) at dilution 1/500, Secondary antibody: Goat anti rabbit IgG at 1/8000 dilution, Exposure time: 1 minute
-
-
其他:
產品詳情
-
Uniprot No.:
-
基因名:
-
別名:Amp antibody; AMPH 1 antibody; AMPH antibody; AMPH_HUMAN antibody; AMPH1 antibody; Amphiphysin (Stiff-Man syndrome with breast cancer 128kD autoantigen) antibody; Amphiphysin (Stiff-Man syndrome with breast cancer 128kDa autoantigen) antibody; Amphiphysin antibody; Amphiphysin I antibody; CG8604 antibody; Damp antibody; dAmph antibody; Dmel\CG8604 antibody; HGNC:471 antibody; MGC49429 antibody; Stiff man syndrome with breast cancer 128kD autoantigen antibody; Stiff man syndrome with breast cancer 128kDa autoantigen antibody
-
宿主:Rabbit
-
反應種屬:Human,Mouse
-
免疫原:Fusion protein of Human AMPH
-
免疫原種屬:Homo sapiens (Human)
-
標記方式:Non-conjugated
-
抗體亞型:IgG
-
純化方式:Antigen affinity purification
-
濃度:It differs from different batches. Please contact us to confirm it.
-
保存緩沖液:-20°C, pH7.4 PBS, 0.05% NaN3, 40% Glycerol
-
產品提供形式:Liquid
-
應用范圍:ELISA,WB,IHC
-
推薦稀釋比:
Application Recommended Dilution ELISA 1:1000-1:5000 WB 1:500-1:2000 IHC 1:50-1:200 -
Protocols:
-
儲存條件:Upon receipt, store at -20°C or -80°C. Avoid repeated freeze.
-
貨期:Basically, we can dispatch the products out in 1-3 working days after receiving your orders. Delivery time maybe differs from different purchasing way or location, please kindly consult your local distributors for specific delivery time.
-
用途:For Research Use Only. Not for use in diagnostic or therapeutic procedures.
相關產品
靶點詳情
-
功能:May participate in mechanisms of regulated exocytosis in synapses and certain endocrine cell types. May control the properties of the membrane associated cytoskeleton.
-
基因功能參考文獻:
- The data show that the dynamin-amphiphysin helices are rearranged to form clusters upon GTP hydrolysis and membrane constriction occurs at protein-uncoated regions flanking the clusters. PMID: 29357276
- We show that AMPH-1/BIN1 binds to nesprin and actin, as well as to the microtubule-binding protein CLIP170 in both species. We propose that BIN1 has a direct and evolutionarily conserved role in nuclear positioning, altered in myopathies. PMID: 26506308
- It is a nerve protein and its autoantibody causes paraneoplastic neurological syndromes. PMID: 25087559
- AMPH1 protein level is reduced in transgenic mouse brain proteins. in the brainstem of nontransgenic and terminally ill JNPL3 transgenic mice. PMID: 22975846
- We propose that antibody-mediated amphiphysin deficiency may account for anxiety behavior in stiff person syndrome PMID: 22331304
- structure-based approach to prediction of peptide-binding behavior of SH3 domain of amphiphysin-1: statistical modeling PMID: 19669081
- investigation of binding affinities of decapeptide ligands with amphiphysin SH3 domain using QSAR models PMID: 20214647
- Female patient with amphiphysin autoantibodies and siff leg syndrome due to small cell cancer of the lung. PMID: 16671079
- Amphiphysin I (Amph I) is a minibrain kinase/dual-specificity tyrosine phosphorylation-regulated kinase substrate. Amph I phosphorylation changes the recruitment of endophilin at the endocytic sites. PMID: 16733250
- This study demonstrates that the analysis of the molecular interaction energy components between peptides and the SH3 domain can successfully characterize the binding interface. PMID: 18206907
- Analyses of Gaussian distribution models showed that diversified properties contribute to the interactions between the SH3 domain and of amphiphysin and peptides. PMID: 18814309
顯示更多
收起更多
-
亞細胞定位:Cytoplasmic vesicle, secretory vesicle, synaptic vesicle membrane; Peripheral membrane protein; Cytoplasmic side. Cytoplasm, cytoskeleton.
-
組織特異性:Neurons, certain endocrine cell types and spermatocytes.
-
數據庫鏈接:
Most popular with customers
-
-
Phospho-YAP1 (S127) Recombinant Monoclonal Antibody
Applications: ELISA, WB, IHC
Species Reactivity: Human
-
-
-
-
-
-